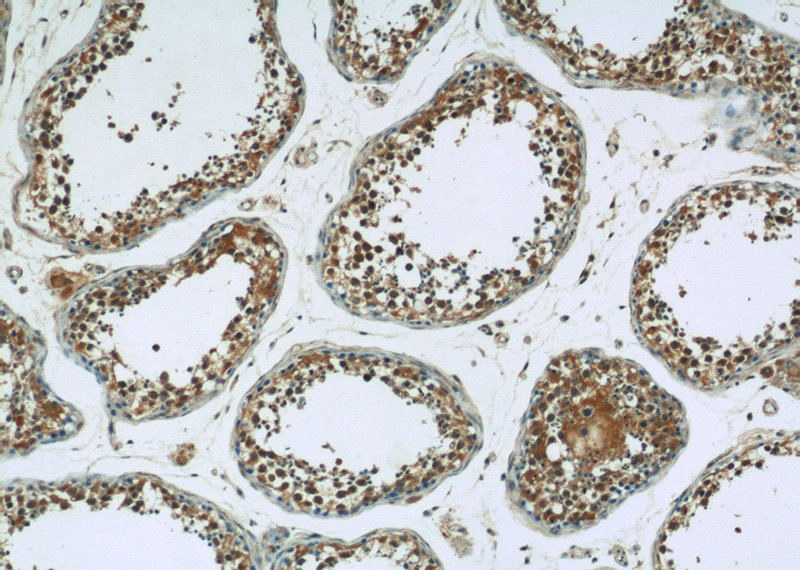
Immunohistochemistry of paraffin-embedded human testis tissue slide using Catalog No:108010(PRKAG1 Antibody) at dilution of 1:50 (under 10x lens)

-
Product Name
AMPK gamma 1 antibody
- Documents
-
Description
AMPK gamma 1 Rabbit Polyclonal antibody. Positive IHC detected in human testis tissue, human skeletal muscle tissue. Positive WB detected in K-562 cells, HeLa cells, Jurkat cells. Observed molecular weight by Western-blot: 35-38 kDa
-
Tested applications
ELISA, WB, IHC
-
Species reactivity
Human,Mouse,Rat; other species not tested.
-
Alternative names
AMPK gamma1 antibody; AMPK subunit gamma 1 antibody; AMPKG antibody; PRKAG1 antibody
-
Isotype
Rabbit IgG
-
Preparation
This antibody was obtained by immunization of AMPK gamma 1 recombinant protein (Accession Number: NM_002733). Purification method: Antigen affinity purified.
-
Clonality
Polyclonal
-
Formulation
PBS with 0.1% sodium azide and 50% glycerol pH 7.3.
-
Storage instructions
Store at -20℃. DO NOT ALIQUOT
-
Applications
Recommended Dilution:
WB: 1:500-1:5000
IHC: 1:20-1:200
-
Validations

K-562 cells were subjected to SDS PAGE followed by western blot with Catalog No:108010(PRKAG1 Antibody) at dilution of 1:1000
Immunohistochemistry of paraffin-embedded human testis tissue slide using Catalog No:108010(PRKAG1 Antibody) at dilution of 1:50 (under 10x lens)

Immunohistochemistry of paraffin-embedded human testis tissue slide using Catalog No:108010(PRKAG1 Antibody) at dilution of 1:50 (under 40x lens)
-
Background
Protein kinase, AMP-activated, gamma 1 non-catalytic subunit (PRKAG1, synonyms: AMPKG, MGC8666) is a regulatory subunit of the AMP-activated protein kinase (AMPK). AMPK is a heterotrimer consisting of an catalytic subunit, and non-catalytic and subunits. AMPK is an important energy-sensing enzyme that monitors cellular energy status. In response to cellular metabolic stresses, AMPK is activated, and thus phosphorylates and inactivates acetyl-CoA carboxylase (ACC) and -hydroxy-methylglutaryl-CoA reductase (HMGCR), key enzymes involved in regulating de novo biosynthesis of fatty acid and cholesterol. This subunit is one of the gamma regulatory subunits of AMPK.
-
References
- Zhu K, Chen X, Liu J, Ye H, Zhu L, Wu JY. AMPK interacts with DSCAM and plays an important role in netrin-1 induced neurite outgrowth. Protein & cell. 4(2):155-61. 2013.
Related Products / Services
Please note: All products are "FOR RESEARCH USE ONLY AND ARE NOT INTENDED FOR DIAGNOSTIC OR THERAPEUTIC USE"
